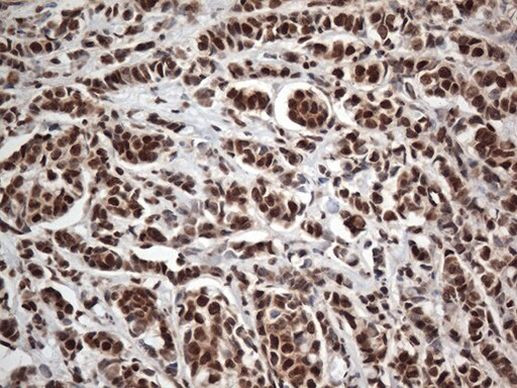
EWSR1 Antibody in Immunohistochemistry (Paraffin) (IHC (P))

Search
OriGene
EWSR1 Monoclonal Antibody (OTI2B3)
{{$productOrderCtrl.translations['antibody.pdp.commerceCard.promotion.promotions']}}
{{$productOrderCtrl.translations['antibody.pdp.commerceCard.promotion.viewpromo']}}
{{$productOrderCtrl.translations['antibody.pdp.commerceCard.promotion.promocode']}}: {{promo.promoCode}} {{promo.promoTitle}} {{promo.promoDescription}}. {{$productOrderCtrl.translations['antibody.pdp.commerceCard.promotion.learnmore']}}
产品信息
TA813053
种属反应
宿主/亚型
分类
类型
克隆号
抗原
偶联物
形式
浓度
规格
纯化类型
保存液
内含物
保存条件
运输条件
靶标信息
This gene encodes a multifunctional protein that is involved in various cellular processes, including gene expression, cell signaling, and RNA processing and transport. The protein includes an N-terminal transcriptional activation domain and a C-terminal RNA-binding domain. Chromosomal translocations between this gene and various genes encoding transcription factors result in the production of chimeric proteins that are involved in tumorigenesis. These chimeric proteins usually consist of the N-terminal transcriptional activation domain of this protein fused to the C-terminal DNA-binding domain of the transcription factor protein. Mutations in this gene, specifically a ttranslocation, are known to cause Ewing sarcoma as well as neuroectodermal and various other tumors. Alternative splicing of this gene results in multiple transcript variants. Related pseudogenes have been identified on chromosomes 1 and 14.
仅用于科研。不用于诊断过程。未经明确授权不得转售。
篇参考文献 (0)
生物信息学
蛋白别名: AC002059.7; chimeric transcription factor; Ewing sarcoma breakpoint region 1; Ewing sarcoma breakpoint region 1 protein; Ewings sarcoma EWS-Fli1 (type 1) oncogene; EWS oncogene; EWSR1; RNA-binding protein EWS; unnamed protein product
基因别名: EWS; EWS-FLI1; EWSR1
UniProt ID: (Human) Q01844
Entrez Gene ID: (Human) 2130